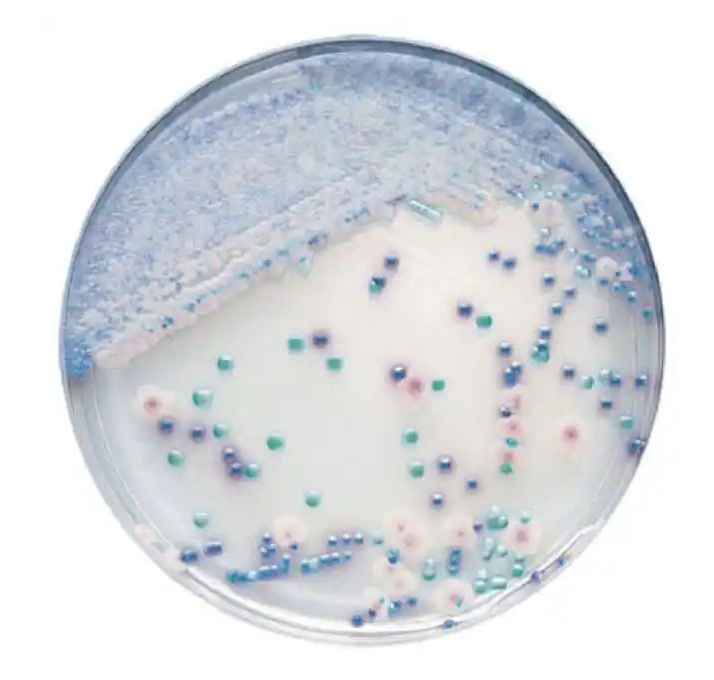
BD CHROMagar Candida, 20 Platten

Nachweis von Dengue-Antigenen & Antikörpern
Für den qualitativen Nachweis der Antigene von Plasmodium
Testkassetten für das Axonlab microINR
Nährmedium in Petrischale
2 mm x 1,5 mm, stärkerer Blutfluss
Universal rot 21 G x 1,8 mm (Einstichtiefe)
für BSG-Röhren Art. 729070
Sediplus® Senkungspipette mit aufgedruckter Skalierung
Sediplus® Senkungspipette ohne Skalierung
für Cobas H232, HBM4; Kühlware
10 x 10 Bürsten im Polybeutel, Länge 20cm
25 Schwangerschaftstestkassetten, Nachweis ab 20mlU/ml
zur Qualitätskontrolle
Nierenfunktionsteststreifen, zum qualitativen Nachweis bereits geringer Mengen Albumin im Urin, lose in einer Dose
hergestellt in Deutschland
in Deutschland hergestellt, inkl. Pipette und Lanzette
Nachweis Dengue-Virus in Vollblut, Serum oder Plasma